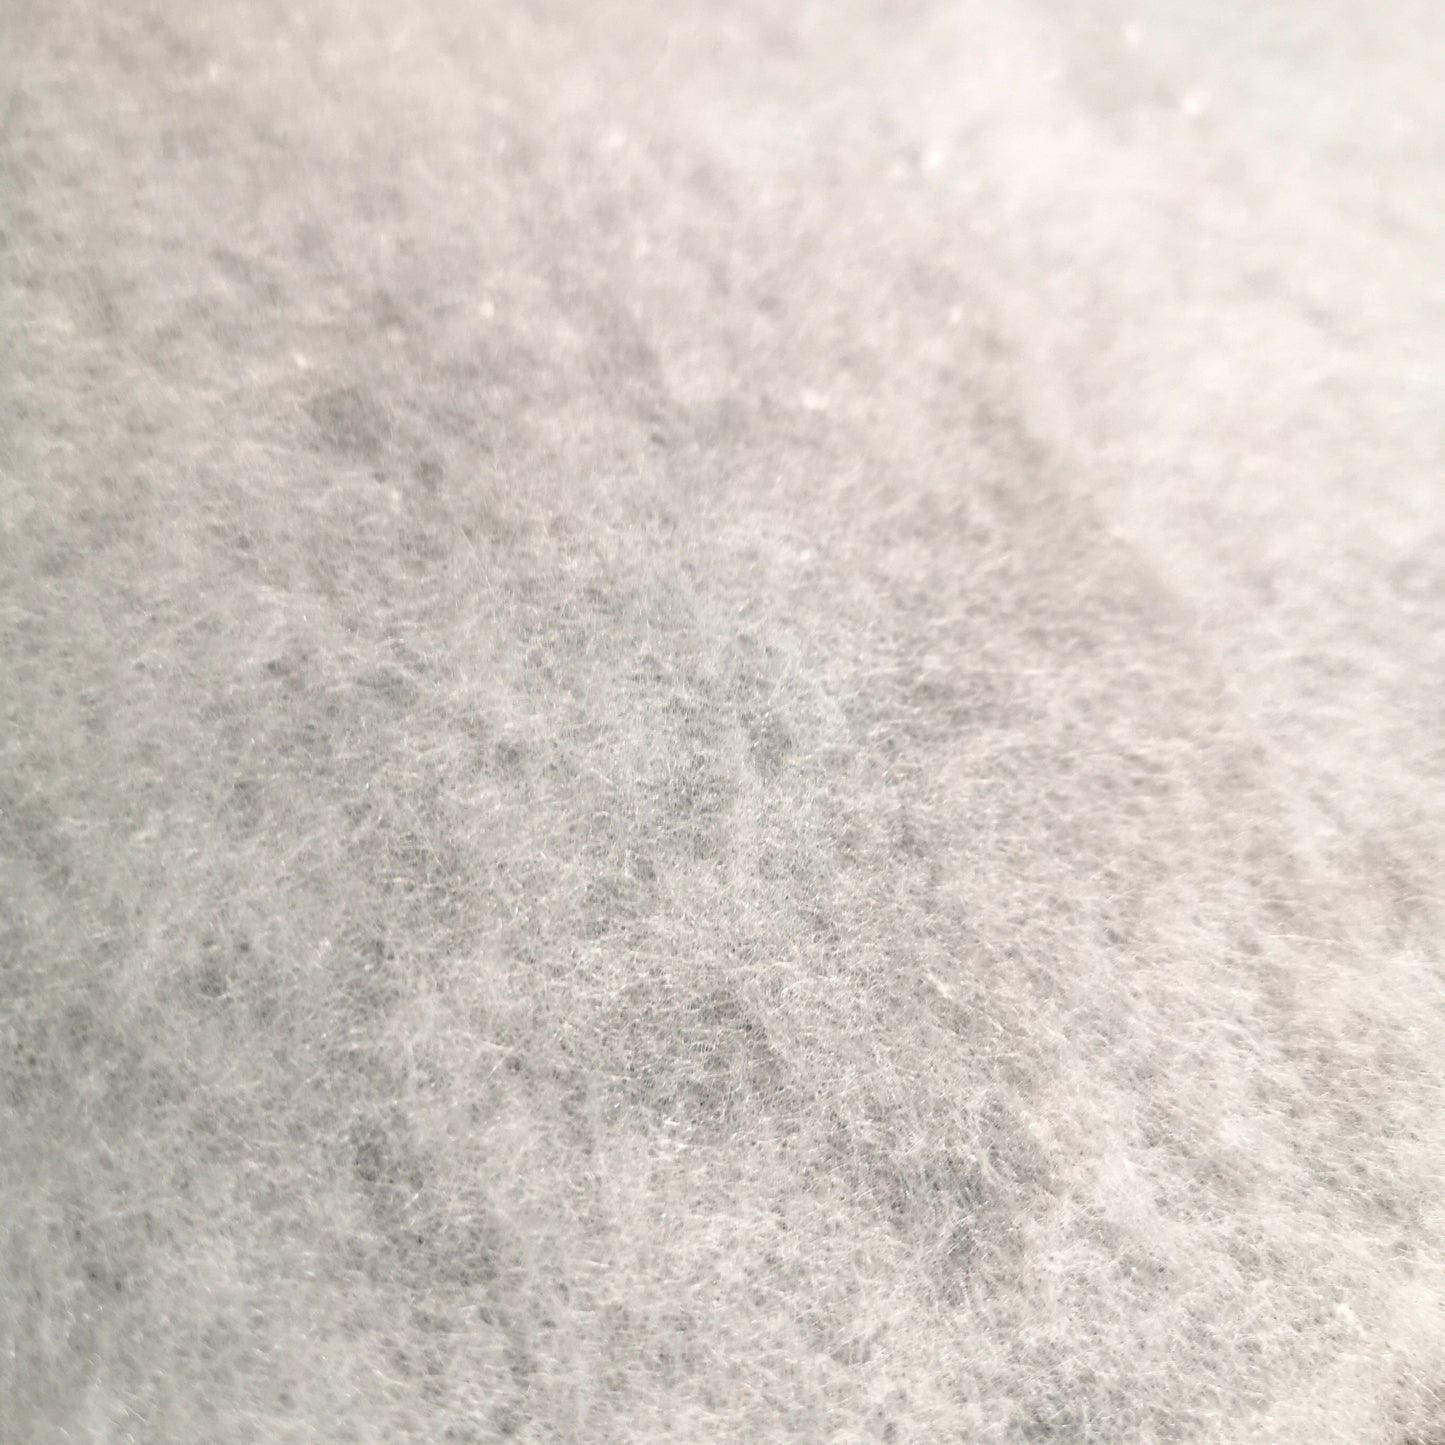
13.5m (44ft) x 90cm Soft White Artificial Fake Snow Blanket Christmas Decoration

Free UK Delivery with every order! See details
- Home
- 13.5m (44ft) x 90cm Soft White Artificial Fake Snow Blanket Christmas Decoration
Description
For the perfect festive display this Christmas use this Artificial Snow Blanket. Featuring a realistic snow appearance, it is the perfect addition to any Christmas decor. This versatile snow blanket can be used alone or as a base for powered snow, snow sparkles and other effects. To install, simply drape the blanket over the desired surfaces and shape to fit your needs. This blanket can be placed anywhere around your home or garden whether you choose to place it on a mantle piece, windowsill or under the Christmas Tree. This artificial snow blanket is a must-have reusable, cost-effective solution for infusing your surroundings with the magic of winter. Dimensions: H90cm x L1350cm (44ft).
Specifications
| Product Specifications | |
| Brand: | Samuel Alexander |
| SKU: | PL20271 |
| Product type: | Artificial Snow |
| Main colour: | White |
Shipping & Return
Reviews
Related Products
Recently viewed products
Shopping cart
close
-
WHAT ARE YOU LOOKING FOR?Search
-
All Categories
-
Christmas
-
Outdoor Living
-
Gardening
-
Homeware
- Home
- Ideas & Advice
- Compare (0)
- Wishlist (0)
- Login / Register
- Contact Us